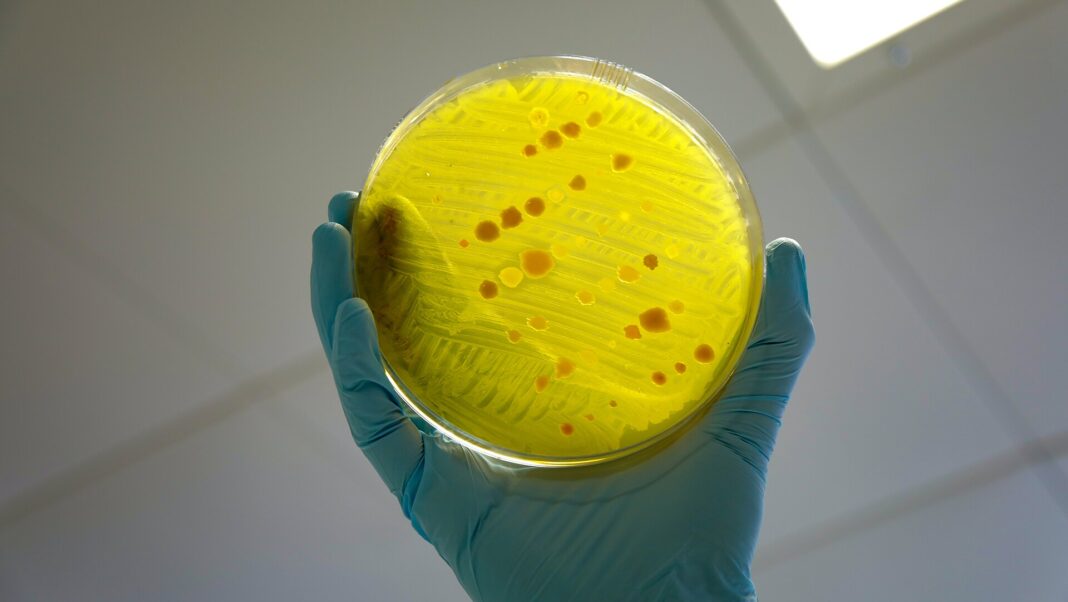

Researchers led by University of Oxford academic Dr Wei Huang have successfully created biologically engineered cells, designed to target antimicrobial-resistant (AMR) bacteria.
Published in the Proceedings of the National Academy of Sciences journal, the study involved developing and testing two types of nonreplicating therapeutic cells named “SimCells” and “Mini-SimCells”. Dr Huang’s team describe these cells as smart “bioparticles” that can selectively eradicate drug-resistant bacteria, whilst sparing non-pathogenic cells.
The testing process saw SimCells targeting a multidrug-resistant strain of E. Coli. Within six hours, the SimCells eliminated more than 85% of the target bacteria, whilst the mini-SimCells eliminated more than 97% within 48 hours. The team utilised a ‘plug and play’ design to create a multipurpose cell that can be reused to target different pathogens by changing the nanobodies on its surface, without rebuilding the basis of the cell.
The study seeks to counter the threat of antimicrobial resistance, which sees microorganisms like bacteria and parasites evolve to resist drugs developed to eradicate them. According to the World Health Organisation, AMR has emerged as “one of the top global health and development threats”, as antimicrobial medications such as antibiotics and antivirals become less effective.
Huang and his research partner, Yun Dong, told Cherwell: “The conventional antibiotic pipeline is failing to keep pace. Our SimCell (simple cell) platform addresses these challenges by offering a new way to fight dangerous drug-resistant bacteria.
“Because they cannot replicate and do not work like standard antibiotics, Sim Cells could provide a safer and more adaptable way to strengthen our diminishing antibiotic arsenal against the world’s most serious AMR pathogens”.
Cumulative projections from the Global Burden of Disease study suggest over 39 million deaths between 2025 and 2050 that would be directly attributed to AMR. The WHO predicts AMR to be the trigger for the next global pandemic, on account of the range of infections and diseases that will be immune to modern medicine. Procedures like cancer chemotherapy, caesarean sections, and organ transplants will also be inhibited. Estimates from the World Bank suggest AMR could result in $1 trillion in additional healthcare costs, and a cumulative global GDP loss of $100 trillion by 2050.
Huang and Dong told Cherwell that rather than the “current paradigm of developing a new small-molecule antibiotic for each resistant pathogen”, the “universal base” of the SimCell makes it not only more effective than antibiotics, but also more efficient. The ‘plug and play’ method bypasses the time and cost-intensive research process for antibiotics, and has the potential to “accelerate the response to AMR outbreaks, reduce development costs, and ultimately contribute to a shift in infectious disease management”.
Huang and Dong told Cherwell they hope to see their work deployed in treating “recurrent urinary tract infections, ventilator-associated pneumonia, or gut decolonisation of MDR carriers”. Whilst the development of new antibiotics has been stagnant since the 1980s, the team believe advancements in synthetic biology have “the potential to reshape how we conceptualise antimicrobial intervention”.